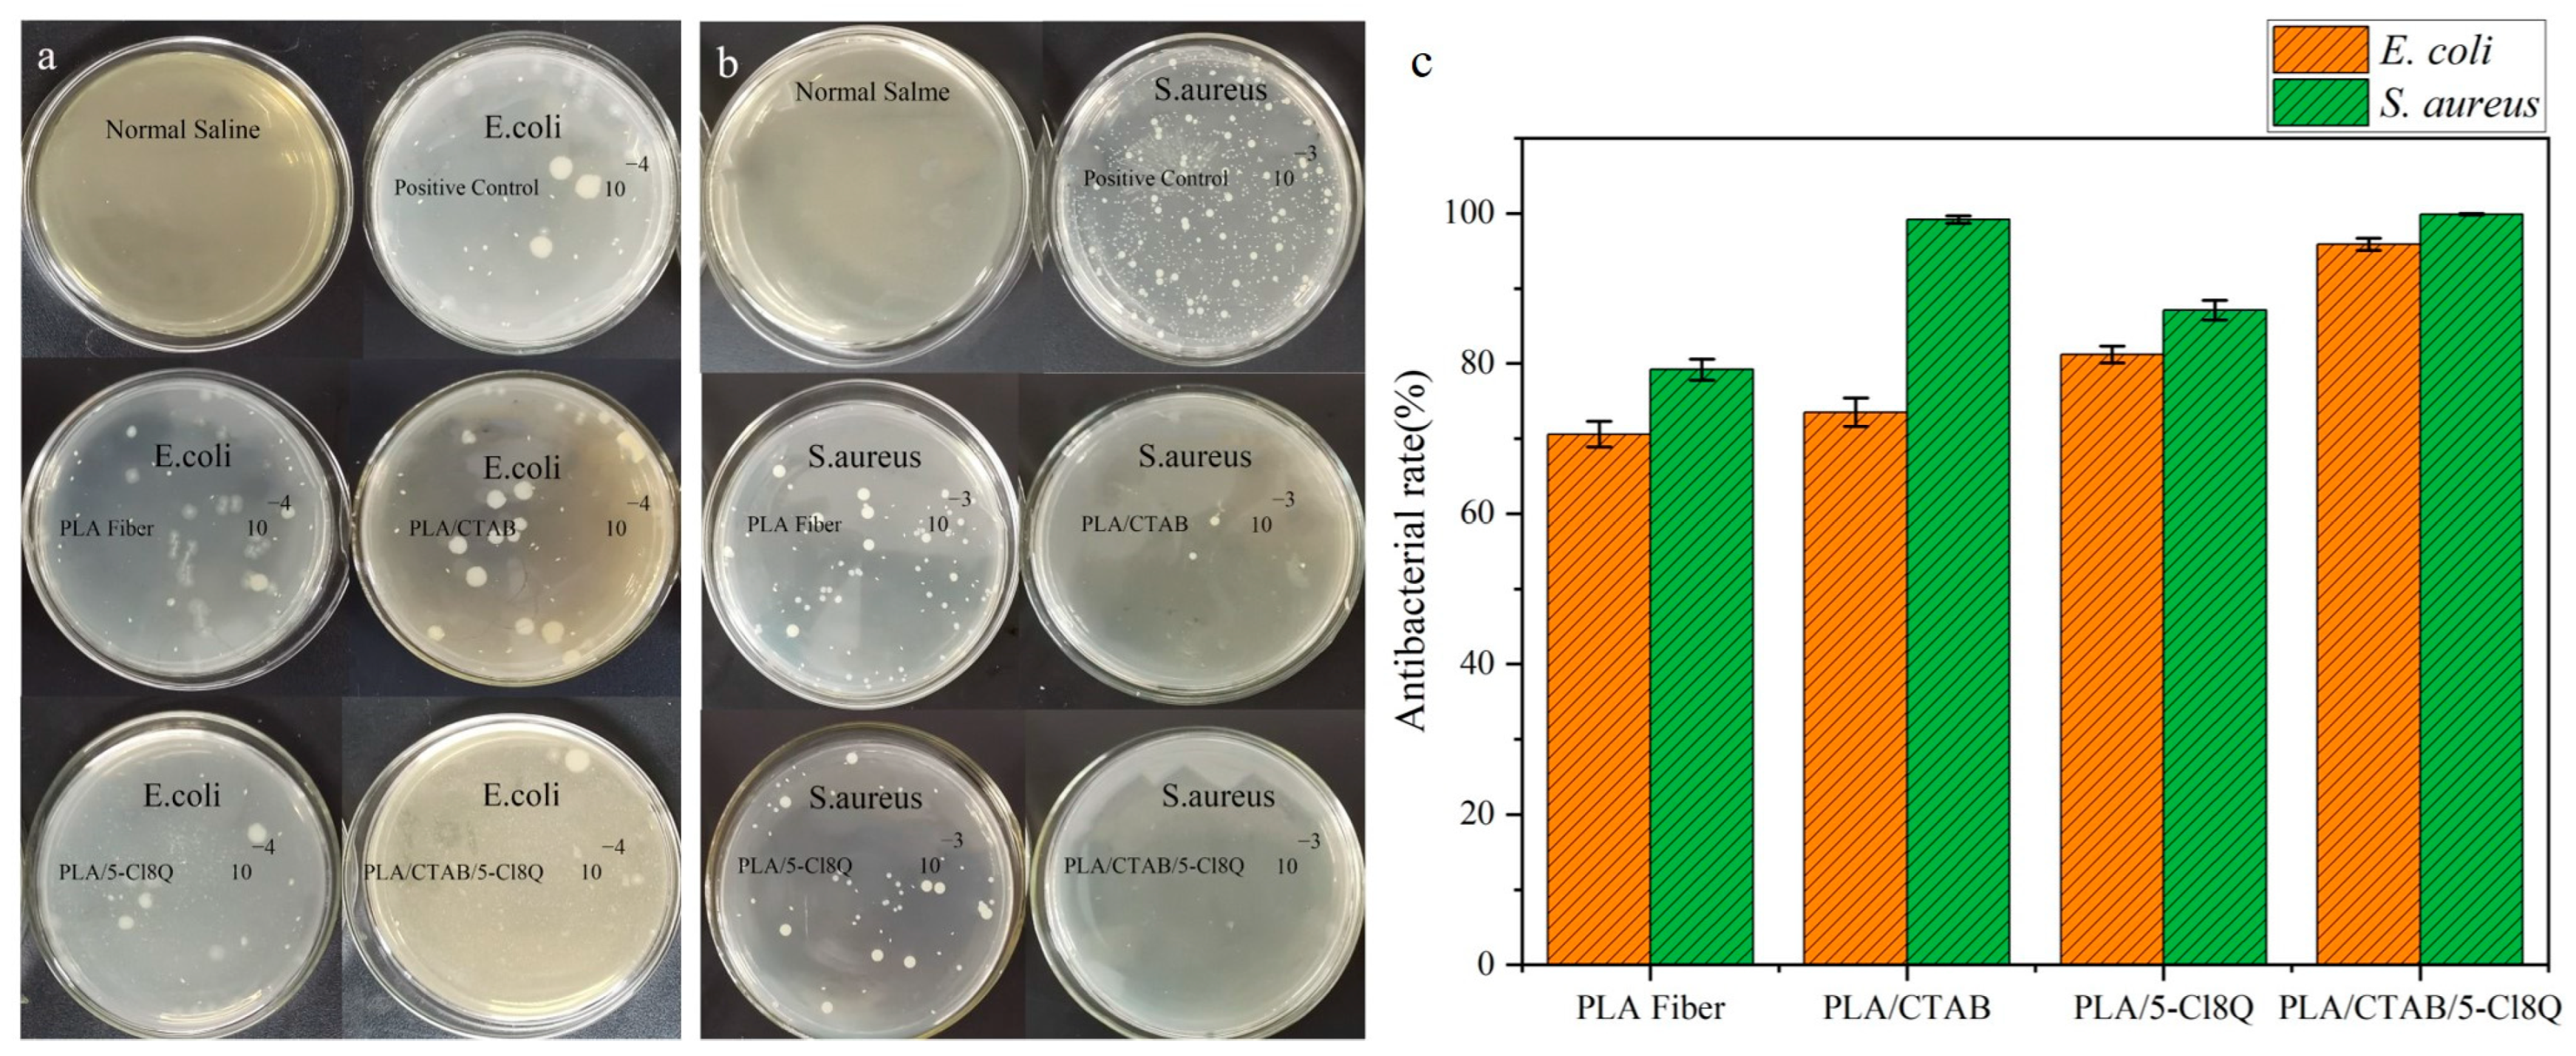
Coatings 13 01686 g007

Preparation and Antibacterial Properties of PLA-Based Composite Nanofiber Membrane Material Loaded with Cationic Antibacterial Agent by Electrospinning
Abstract
:1. Introduction
2. Materials and Methods
2.1. Materials
2.2. Preparation of Fibers
2.2.1. Preparation of PLA Fiber Film
2.2.2. Preparation of PLA/CTAB Fiber Film
2.2.3. Preparation of PLA/5-Cl8Q Fiber Film
2.2.4. Preparation of PLA/CTAB/5-Cl8Q Fiber Film
2.3. Characterization
2.4. Antibacterial Test
2.5. Statistical Analysis
3. Results and Discussion
3.1. Characterization of Fiber Films
3.2. Antibacterial Analysis
4. Conclusions
Supplementary Materials
Author Contributions
Funding
Institutional Review Board Statement
Informed Consent Statement
Data Availability Statement
Conflicts of Interest
References
- Bedford, J.; Farrar, J.; Ihekweazu, C.; Kang, G.; Koopmans, M.; Nkengasong, J. A new twenty-first century science for effective epidemic response. Nature 2019, 575, 130–136. [Google Scholar] [CrossRef] [PubMed]
- Xu, X.C.; Zhang, J.; Liu, S.; Wang, C.H.; Wang, H.Y.; Fan, H.H.; Tong, Y.G.; Liu, H.Y.; Zhou, D.S. New Advances in Nanomaterial-Based Antiviral Strategies. Small Struct. 2022, 3, 2200021. [Google Scholar] [CrossRef]
- Tiri, R.N.E.; Gulbagca, F.; Aygun, A.; Cherif, A.; Sen, F. Biosynthesis of Ag–Pt bimetallic nanoparticles using propolis extract: Antibacterial effects and catalytic activity on NaBH4 hydrolysis. Environ. Res. 2022, 206, 112622. [Google Scholar] [CrossRef] [PubMed]
- Wang, S.Y.; Duan, Y.O.; Zhang, Q.Z.; Komarla, A.; Gong, H.; Gao, W.W.; Zhang, L.F. Drug Targeting via Platelet Membrane-Coated Nanoparticles. Small Struct. 2020, 1, 2000018. [Google Scholar] [CrossRef]
- Varela, M.F.; Stephen, J.; Lekshmi, M.; Ojha, M.; Wenzel, N.; Sanford, L.M.; Hernandez, A.J.; Parvathi, A.; Kumar, S.H. Bacterial Resistance to Antimicrobial Agents. Antibiotics 2021, 10, 593. [Google Scholar] [CrossRef] [PubMed]
- Ding, J.; Zhang, J.; Li, J.; Li, D.; Xiao, C.; Xiao, H.; Yang, H.; Zhuang, X.; Chen, X. Electrospun polymer biomaterials. Prog. Polym. Sci. 2019, 90, 1–34. [Google Scholar] [CrossRef]
- Zhang, C.; Li, Y.; Wang, P.; Zhang, H. Electrospinning of nanofibers: Potentials and perspectives for active food packaging. Compr. Rev. Food Sci. Food Saf. 2020, 19, 479–502. [Google Scholar] [CrossRef]
- Shi, S.; Si, Y.F.; Han, Y.T.; Wu, T.; Iqbal, M.I.; Fei, B.; Li, R.K.Y.; Hu, J.L.; Qu, J.P. Recent Progress in Protective Membranes Fabricated via Electrospinning: Advanced Materials, Biomimetic Structures, and Functional Applications. Adv. Mater. 2022, 34, 2107938. [Google Scholar] [CrossRef]
- Wang, X.M.; Sun, F.Z.; Yin, G.C.; Wang, Y.T.; Liu, B.; Dong, M.D. Tactile-Sensing Based on Flexible PVDF Nanofibers via Electrospinning: A Review. Sensors 2018, 18, 330. [Google Scholar] [CrossRef]
- Armentano, I.; Bitinis, N.; Fortunati, E.; Mattioli, S.; Rescignano, N.; Verdejo, R.; Lopez-Manchado, M.A.; Kenny, J.M. Multifunctional nanostructured PLA materials for packaging and tissue engineering. Prog. Polym. Sci. 2013, 38, 1720–1747. [Google Scholar] [CrossRef]
- Wu, J.H.; Hu, T.G.; Wang, H.; Zong, M.H.; Wu, H.; Wen, P. Electrospinning of PLA Nanofibers: Recent Advances and Its Potential Application for Food Packaging. J. Agric. Food Chem. 2022, 70, 8207–8221. [Google Scholar] [CrossRef] [PubMed]
- Liu, C.Y.; Du, G.C.; Guo, Q.Q.; Li, R.G.; Li, C.M.; He, H.W. Fabrication and Characterization of Polylactic Acid Electrospun Wound Dressing Modified with Polyethylene Glycol, Rosmarinic Acid and Graphite Oxide. Nanomaterials 2023, 13, 2000. [Google Scholar] [CrossRef] [PubMed]
- He, X.; Zhou, M.L.; Chen, X.M.; Wang, J.; Zhao, X.L.; Zhu, Y.X.; Liu, T. Development and Characterization of Multifunctional Wound Dressing with the Property of Anti-bacteria and Angiogenesis. Probiotics Antimicrob. Proteins 2022, 15, 941–954. [Google Scholar] [CrossRef] [PubMed]
- Balakrishnan, N.K.; Ostheller, M.E.; Aldeghi, N.; Schmitz, C.; Groten, R.; Seide, G. Pilot-Scale Electrospinning of PLA Using Biobased Dyes as Multifunctional Additives. Polymers 2022, 14, 2989. [Google Scholar] [CrossRef] [PubMed]
- Nedelcu, I.A.; Ficai, A.; Sonmez, M.; Ficai, D.; Oprea, O.; Andronescu, E. Silver Based Materials for Biomedical Applications. Curr. Org. Chem. 2014, 18, 173–184. [Google Scholar] [CrossRef]
- Allizond, V.; Banche, G.; Salvoni, M.; Malandrino, M.; Cecone, C.; Cuffini, A.M.; Bracco, P. Facile One-Step Electrospinning Process to Prepare AgNPs-Loaded PLA and PLA/PEO Mats with Antibacterial Activity. Polymers 2023, 15, 1470. [Google Scholar] [CrossRef]
- Tran, C.D.; Prosenc, F.; Franko, M.; Benzi, G. One-Pot Synthesis of Biocompatible Silver Nanoparticle Composites from Cellulose and Keratin: Characterization and Antimicrobial Activity. Acs Appl. Mater. Interfaces 2016, 8, 34791–34801. [Google Scholar] [CrossRef] [PubMed]
- Fijalkowski, K.; Rorat, A.; Grobelak, A.; Kacprzak, M.J. The presence of contaminations in sewage sludge—The current situation. J. Environ. Manag. 2017, 203, 1126–1136. [Google Scholar] [CrossRef]
- Zhao, S.Y.; Huang, W.J.; Wang, C.R.; Wang, Y.P.; Zhang, Y.F.; Ye, Z.P.; Zhang, J.H.; Deng, L.D.; Dong, A.J. Screening and Matching Amphiphilic Cationic Polymers for Efficient Antibiosis. Biomacromolecules 2020, 21, 5269–5281. [Google Scholar] [CrossRef]
- Lu, S.C.; Zhang, X.H.; Tang, Z.W.; Xiao, H.; Zhang, M.; Liu, K.; Chen, L.H.; Huang, L.L.; Ni, Y.H.; Wu, H. Mussel-inspired blue-light-activated cellulose-based adhesive hydrogel with fast gelation, rapid haemostasis and antibacterial property for wound healing. Chem. Eng. J. 2021, 417, 129329. [Google Scholar] [CrossRef]
- Chiloeches, A.; Fernandez-Garcia, R.; Fernandez-Garcia, M.; Mariano, A.; Bigioni, I.; d’Abusco, A.S.; Echeverria, C.; Munoz-Bonilla, A. PLA and PBAT-Based Electrospun Fibers Functionalized with Antibacterial Bio-Based Polymers. Macromol. Biosci. 2023, 23, e2200401. [Google Scholar] [CrossRef]
- Batra, R.; Purwar, R.; Kulanthaivel, S.; Mishra, P. Cetyl Trimethyl Ammonium Bromide Modified Montmorillonite-Doped Tasar Silk Fibroin/Polyvinyl Alcohol Blend 3D Nanowebs for Tissue Engineering Applications. Macromol. Mater. Eng. 2021, 306, 2100450. [Google Scholar] [CrossRef]
- Nachev, N.; Spasova, M.; Tsekova, P.; Manolova, N.; Rashkov, I.; Naydenov, M. Electrospun Polymer-Fungicide Nanocomposites for Grapevine Protection. Polymers 2021, 13, 3673. [Google Scholar] [CrossRef] [PubMed]
- Dong, W.; Green, J.; Korza, G.; Setlow, P. Killing of spores of Bacillus species by cetyltrimethylammonium bromide. J. Appl. Microbiol. 2019, 126, 1391–1401. [Google Scholar] [CrossRef] [PubMed]
- Spasova, M.; Manolova, N.; Rashkov, I.; Naydenov, M. Electrospun 5-chloro-8-hydroxyquinoline-Loaded Cellulose Acetate/Polyethylene Glycol Antifungal Membranes Against Esca. Polymers 2019, 11, 1617. [Google Scholar] [CrossRef] [PubMed]
- Ke, W.C.; Li, X.; Miao, M.Y.; Liu, B.; Zhang, X.Y.; Liu, T. Fabrication and Properties of Electrospun and Electrosprayed Polyethylene Glycol/Polylactic Acid (PEG/PLA) Films. Coatings 2021, 11, 790. [Google Scholar] [CrossRef]
- Yang, C.Y.; Chen, S.H.; Wang, J.H.; Zhu, T.H.; Xu, G.; Chen, Z.C.; Ma, X.B.; Li, W.Y. A facile electrospinning method to fabricate polylactide/graphene/MWCNTs nanofiber membrane for tissues scaffold. Appl. Surf. Sci. 2016, 362, 163–168. [Google Scholar] [CrossRef]
- Wu, J.; Liu, S.; Zhang, M.; Wu, G.; Yu, H.; Li, H.; Li, F.; Jia, L. Coaxial electrospinning preparation and antibacterial property of polylactic acid/tea polyphenol nanofiber membrane. J. Ind. Text. 2022, 51, 1778S–1792S. [Google Scholar] [CrossRef]
- Spasova, M.; Manolova, N.; Rashkov, I.; Tsekova, P.; Georgieva, A.; Toshkova, R.; Markova, N. Cellulose Acetate-Based Electrospun Materials with a Variety of Biological Potentials: Antibacterial, Antifungal and Anticancer. Polymers 2021, 13, 1631. [Google Scholar] [CrossRef]

Disclaimer/Publisher’s Note: The statements, opinions and data contained in all publications are solely those of the individual author(s) and contributor(s) and not of MDPI and/or the editor(s). MDPI and/or the editor(s) disclaim responsibility for any injury to people or property resulting from any ideas, methods, instructions or products referred to in the content. |
© 2023 by the authors. Licensee MDPI, Basel, Switzerland. This article is an open access article distributed under the terms and conditions of the Creative Commons Attribution (CC BY) license (https://creativecommons.org/licenses/by/4.0/).
Share and Cite
Gong, H.; Li, L.; Li, N.; Tian, L.; Zhang, T.; Zhang, L.; Jiao, T. Preparation and Antibacterial Properties of PLA-Based Composite Nanofiber Membrane Material Loaded with Cationic Antibacterial Agent by Electrospinning. Coatings 2023, 13, 1686. https://doi.org/10.3390/coatings13101686
Gong H, Li L, Li N, Tian L, Zhang T, Zhang L, Jiao T. Preparation and Antibacterial Properties of PLA-Based Composite Nanofiber Membrane Material Loaded with Cationic Antibacterial Agent by Electrospinning. Coatings. 2023; 13(10):1686. https://doi.org/10.3390/coatings13101686
Chicago/Turabian StyleGong, Hongyu, Lin Li, Na Li, Lina Tian, Tao Zhang, Lexin Zhang, and Tifeng Jiao. 2023. "Preparation and Antibacterial Properties of PLA-Based Composite Nanofiber Membrane Material Loaded with Cationic Antibacterial Agent by Electrospinning" Coatings 13, no. 10: 1686. https://doi.org/10.3390/coatings13101686
APA StyleGong, H., Li, L., Li, N., Tian, L., Zhang, T., Zhang, L., & Jiao, T. (2023). Preparation and Antibacterial Properties of PLA-Based Composite Nanofiber Membrane Material Loaded with Cationic Antibacterial Agent by Electrospinning. Coatings, 13(10), 1686. https://doi.org/10.3390/coatings13101686

